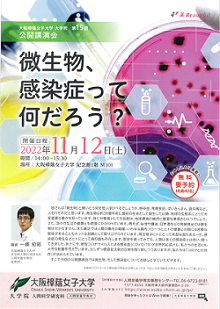

【第15回公開講演会】微生物、感染症って何だろう?
【講座内容】
皆さんは「微生物」と聞いたら何を思い浮かべるでしょうか。
感染症、発酵食品、ばいきんまん、食中毒など、人それぞれだと思います。
微生物は約38億年前に最初の生命として誕生して以降、地球の生態系にとって大変重要な働きを担っています。特に分解者としての役割は、地球環境の維持に重要な事柄のひとつでしょう。また、我々の生活や健康とも密接にかかわっています。例えば、味噌や醤油、日本酒などの発酵食品には微生物は欠かせません。また最近では人間の腸内の細菌、いわゆる腸内フローラとヒトの健康との間には密接な関係があることもホットな話題として取り上げられています。
微生物はヒトにとって有益な面もある一方、感染症の発生などヒトにとって負の面も存在します。歴史を遡ってみても、人類は多くの感染症と出会い、闘ってきました。まさに今、新型コロナウイルスによる感染症(COVID-19)が世界的に拡大し、私たちの生活にも大きな影響を与えています。少しずつ感染拡大前の日常を取り戻しつつありますが、私たちは「コロナとの共存」が求められています。そこで今回の公開講演会では微生物、そして感染症についてお話しさせていただきます。
【講師】
大学院人間科学研究科 人間栄養学専攻
一條 知昭 准教授
【詳細】
日 時 : 2022年11月12日(土) 14:00~15:30
場 所 : 大阪樟蔭女子大学 記念館1階 M101
受 講 料 : 無料
【申込締切について】
※申込締切:2022年11月10日(木)必着 《先着順》
※申込の受付後は、本学より受付完了の旨、ご連絡いたします。
お申込後、1週間経っても本学より連絡がない場合は、お手数ですが下記までお問合せください。
| 問合せ先 大阪樟蔭女子大学大学院 人間科学研究科 人間栄養学専攻事務センター 〒577-8550 東大阪市菱屋西4-2-26 電 話 : 06-6723-8181(内線6217) FAX : 06-7507-1045 |
【HPでの申込】
申込フォームより、必要事項をご入力の上、お申込ください。
申込フォーム
【FAXでの申込】
下記FAX申込用紙に、必要事項をご記入の上、FAXでお送りください。
FAX番号 : 06-7507-1045
申込フォーム(FAX送信用)
【ハガキでの申込】
①氏名(ふりがな) ②住所 ③電話番号 ④公開講演会『微生物、感染症って何だろう?』をご記入の上、上記の申込先へお送りください。
【アクセス方法】
近鉄奈良線「河内小阪駅」下車 西へ徒歩300メートル
JRおおさか東線「JR河内永和駅」下車 東へ徒歩400メートル
※駐車場はございませんので、お車でのご来場はご遠慮ください。
地図 アクセス
